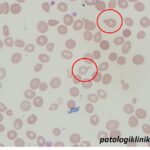
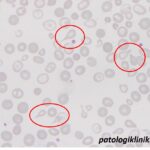
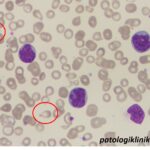
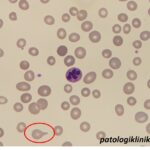
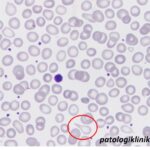
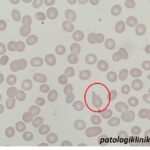
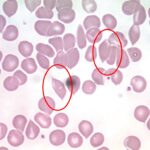

Sel Teardrop atau Dacrocyte
Sel teardrop atau dacrocyte adalah gambaran berbentuk seperti tetesan air, dengan bentuk bulat tumpul di satu sisi dan tipis meruncing di sisi lain.
Gambaran mirip sel teardrop:
- sel teardrop artifisial: karena pembuatan preparat, biasanya ujung runcingnya mengarah pada satu sisi, sesuai pembuatan preparatnya.
- pseudo-teardrop: karena tekanan dari eritrosit lain, biasanya bukan pada area hitung, dengan ciri pada kedua sisi ada ujung runcing (tidak membulat)
Mekanisme terbentuknya sel teardrop:
- perubahan mekanis dari membran dan sitoskeleten eritrosit akibat fibrosis pada sumsum tulang
- hematopoiesis ekstrameduler pada limpa memaksa eritrosit keluar ke sirkulasi melewati sinusoid limpa yang rapat
- pengeluaran badan inklusi eritrosit di dalam limpa, menyebabkan perubahan bentuk eritrosit.
Sel teardrop ditemukan pada kondisi:
- mielofibrosis (primer dan sekunder)
- penyakit mieloproliferatif yang lain
- thalassemia β mayor dan intermedia
- anemia hemolitik
- leukemia akut
- metastasis tumor solid ke sumsum tulang
- anemia megaloblastik (jarang)
- MDS (jarang)
- anemia defisiensi Fe (jarang)
- anemia sideroblastik (jarang)
Semoga bermanfaat
Sumber:
Gutgemann, et al. Significance of teardrop cells in peripheral blood smears. J Lab Med 2014-0005